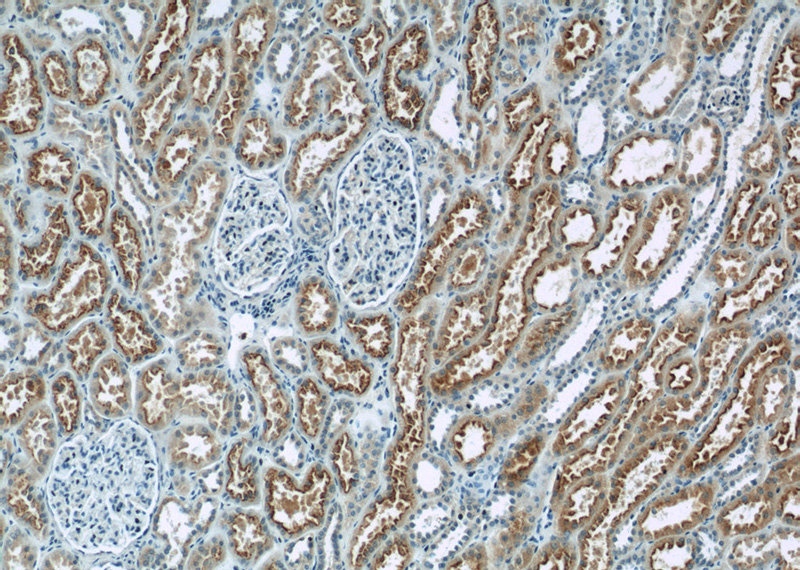
Immunohistochemistry of paraffin-embedded human kidney tissue slide using Catalog No:112671(TMEM67 Antibody) at dilution of 1:50 (under 10x lens)
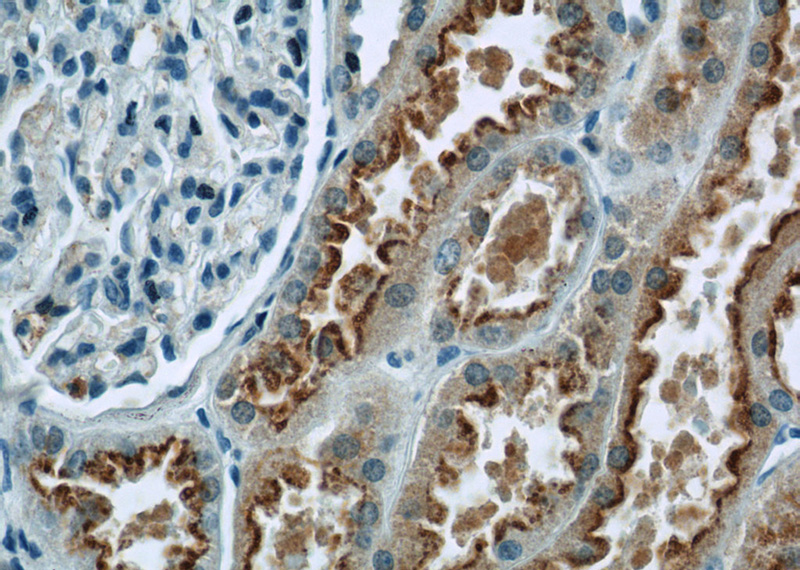
Immunohistochemistry of paraffin-embedded human kidney tissue slide using Catalog No:112671(TMEM67 Antibody) at dilution of 1:50 (under 40x lens)

-
Product Name
MKS3 antibody
- Documents
-
Description
MKS3 Rabbit Polyclonal antibody. Positive IF detected in hTERT-RPE1 cells. Positive IHC detected in human kidney tissue, human hepat℃irrhosis tissue.
-
Tested applications
ELISA, IF, IHC
-
Species reactivity
Human, Mouse; other species not tested.
-
Alternative names
JBTS6 antibody; Meckel syndrome type 3 protein antibody; MECKELIN antibody; MKS3 antibody; TMEM67 antibody; TNEM67 antibody; transmembrane protein 67 antibody
-
Isotype
Rabbit IgG
-
Preparation
This antibody was obtained by immunization of MKS3 recombinant protein (Accession Number: BC032835). Purification method: Antigen affinity purified.
-
Clonality
Polyclonal
-
Formulation
PBS with 0.02% sodium azide and 50% glycerol pH 7.3.
-
Storage instructions
Store at -20℃. DO NOT ALIQUOT
-
Applications
Recommended Dilution:
IHC: 1:20-1:200
IF: 1:20-1:200
-
Validations

IF result from Dr. Corbit, Kevin. anti-MKS3(Catalog No:112671) marks the proximal transition zone and basal body of Human hTERT-RPE1 cells and Mouse embryonic fibroblasts.
Immunohistochemistry of paraffin-embedded human kidney tissue slide using Catalog No:112671(TMEM67 Antibody) at dilution of 1:50 (under 10x lens)
Immunohistochemistry of paraffin-embedded human kidney tissue slide using Catalog No:112671(TMEM67 Antibody) at dilution of 1:50 (under 40x lens)
-
Background
TMEM67 represents transmembrane protein 67
-
References
- Garcia-Gonzalo FR, Corbit KC, Sirerol-Piquer MS. A transition zone complex regulates mammalian ciliogenesis and ciliary membrane composition. Nature genetics. 43(8):776-84. 2011.
- Goetz SC, Liem KF, Anderson KV. The spinocerebellar ataxia-associated gene Tau tubulin kinase 2 controls the initiation of ciliogenesis. Cell. 151(4):847-58. 2012.
- Wang WJ, Tay HG, Soni R. CEP162 is an axoneme-recognition protein promoting ciliary transition zone assembly at the cilia base. Nature cell biology. 15(6):591-601. 2013.
- Yang Y, Ran J, Liu M. CYLD mediates ciliogenesis in multiple organs by deubiquitinating Cep70 and inactivating HDAC6. Cell research. 24(11):1342-53. 2014.
- Barbelanne M, Hossain D, Chan DP, Peränen J, Tsang WY. Nephrocystin proteins NPHP5 and Cep290 regulate BBSome integrity, ciliary trafficking and cargo delivery. Human molecular genetics. 24(8):2185-200. 2015.
- Roberson EC, Dowdle WE, Ozanturk A. TMEM231, mutated in orofaciodigital and Meckel syndromes, organizes the ciliary transition zone. The Journal of cell biology. 209(1):129-42. 2015.
- Ran J, Yang Y, Li D, Liu M, Zhou J. Deacetylation of α-tubulin and cortactin is required for HDAC6 to trigger ciliary disassembly. Scientific reports. 5:12917. 2015.
- Lu Q, Insinna C, Ott C. Early steps in primary cilium assembly require EHD1/EHD3-dependent ciliary vesicle formation. Nature cell biology. 17(4):531. 2015.
Related Products / Services
Please note: All products are "FOR RESEARCH USE ONLY AND ARE NOT INTENDED FOR DIAGNOSTIC OR THERAPEUTIC USE"
